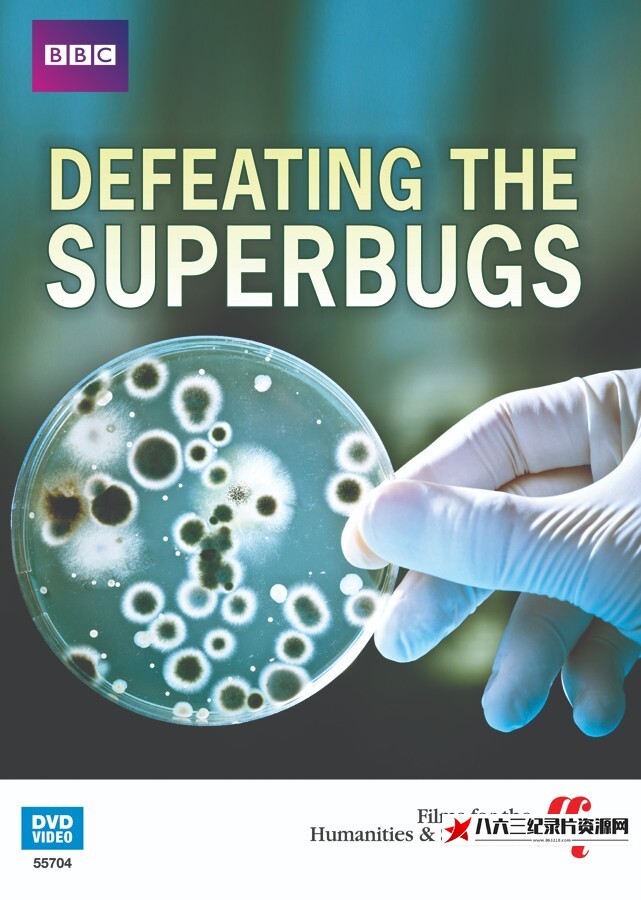
抗击超级细菌 Defeating the Superbugs的海报

抗击超级细菌 Defeating the Superbugs
- 类型: 科学
- 出品方: BBC
- 制片国家/地区: 英国
- 语言: 英语
- 首播: 2012
- 集数: 1
- 所属系列: BBC 地平线系列 Horizon
在世界各地,我们已经看到流氓细菌的出现。 这些都是超级病菌,危险的细菌正在抵抗我们唯一的防御:抗生素。 在世界各地跟踪这些潜在杀手蔓延的科学家,研究人员正在开发击败这些超级细菌的新技术。抗生素是人类医学史上的一大奇迹,自诞生以来拯救了无数生命。但如今,由于人们滥用抗生素、药厂随意排放污水、肉畜饲料中大量添加抗生素等问题,细菌渐渐产生了强大的抗药性,致命的“超级细菌”出现在全球各地,让医生束手无策。
© 版权声明
文章版权归作者所有,未经允许请勿转载。
THE END

暂无评论内容